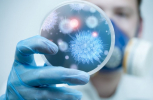

Здоров'я
Наша шкіра – як кора дерева, з часом покривається наростами. На тілі людини переважно з'являються папіломи, кератоми, невуси та інші доброякісні новоутворення. Але серед них можуть приховуватися і злоякісні, які виявити може тільки лікар дерматолог за допомогою дерматоскопа на ранніх стадіях.